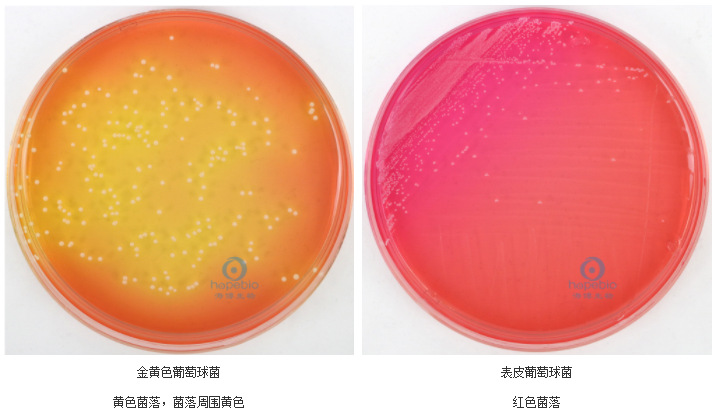
甘露醇高盐琼脂 mannitol salt agar hb4128 250g 青岛海博生物

mannitol

introduction of mannitol
图片尺寸400x267
甘露醇高盐琼脂 mannitol salt agar hb4128 250g 青岛海博生物
图片尺寸718x416
top quality mannitol powder
图片尺寸700x467
dmannitold甘露醇
图片尺寸567x808
赤藓糖醇(erythritol),麦芽糖醇(maltitol),甘露醇(mannitol),山梨
图片尺寸890x589
d-mannitol_datasheet_medchemexpress
图片尺寸331x331
mannitol powder (1 lb) sugar free sweetener, easy mix in
图片尺寸880x573
gmp pharmaceutical grade bp2008/usp31/cp2010 mannitol
图片尺寸712x528
英文名称:mannitol salt agar产品货号:hb4128产品规格:250g产品价格
图片尺寸650x650
69-65-8,d-甘露醇,d-mannitol,adamas,77529b,01106684,mfcd00064287
图片尺寸1055x439
广州现货供应山东天力甘露醇 mannitol甜味剂
图片尺寸1920x1920
招商广场招商信息
图片尺寸383x620
甘露醇注射液
图片尺寸1060x1855
d-甘露醇(d-mannitol)
图片尺寸302x127
mannitolsinjection300mld甘露醇山梨糖醇注射液
图片尺寸300x225
甘露醇,d-mannitol
图片尺寸300x300
甘露醇的正确打开方式!
图片尺寸440x582
我的菊花里爬出一条绦虫医生我从业30年都没见过你这病例
图片尺寸1080x1440
d-mannitol
图片尺寸640x360
甘露醇氯化钠琼脂mannitolsaltagar
图片尺寸1800x1668